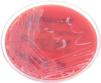

Se trata de una mujer de 39 años, previamente sana, que acudió a Urgencias por presentar tumoración en región cervical izquierda de crecimiento progresivo, de 15 días de evolución, acompañada de prurito y sudoración nocturna. Sin dolor ni distermia. Ha recibido antiinflamatorio y espiramicina más metronidazol durante una semana sin mejoría. Como antecedentes destacan migraña y rinitis alérgica. No refiere contacto con animales ni consumo de productos lácteos crudos. A la exploración física aparece un bulto fijo, que ocupaba 1/3 superior del hemicuello izquierdo, no doloroso y sin inflamación (fig. 1). No existían adenopatías en cuello derecho ni en el resto de la exploración. En la nasofibroscopia se observó mucosa normal. Se decidió su hospitalización para estudio.
La analítica inicial reveló leucocitosis 12,2×109/l, neutrofilia 9,64×109L, VSG 49mm/h, PCR 3,39mg/dl. Las serologías de (VIH, VHB, VHC, VEB, CMV, sífilis) fueron negativas. En la TAC de cuello y tórax aparecía una masa multinodular en el cuello izquierdo nivel IIA-IIB y III con necrosis central de 4×2,8cm (fig. 2). La radiografía de tórax era normal. Se sospechó etiología infecciosa o enfermedad linfoproliferativa. Se practicó PAAF que fue no concluyente por escasa muestra.
Se trató empíricamente con cefazolina 1g/8h más metilprednisolona 40mg/12h. Tras 9 días de tratamiento y escasa mejoría, se realizó biopsia para estudio. El examen histopatológico destaca necrosis pero no malignidad. En el cultivo microbiológico se aisló un cocobacilo, gram, catalasa y ureasa positivos, con pirazinamidasa y fosfatasa alcalina negativas.
EvoluciónLa bacteria se identificó como Corynebacterium pseudotuberculosis (C. pseudotuberculosis) (fig. 3) mediante API-Coryne (Biomerieux®) y se confirmó mediante espectrometría de masas (MALDI-TOF Bruker Byotiper), con un score de 2,339 en hospital de referencia. Se realizó antibiograma siguiendo criterios EUCAST. Se obtuvo susceptibilidad a penicilina, clindamicina, rifampicina, tetraciclina, vancomicina, ciprofloxacino y linezolid y resistencia a gentamicina.
Se trató con eritromicina oral, aunque tuvo una evolución lenta precisando reingreso a la semana, para tratamiento parenteral con clindamicina (600mg/8h) más amoxicilina-clavulánico (1g/8h) durante 7 días. Tras mejoría se da alta con eritromicina oral (500mg/8h) dos semanas más, con resolución completa del cuadro.
Comentario finalLas principales causas de linfadenitis son infecciosas o tumorales. Dentro de las causas infecciosas, pueden ser agudas (bacterianas o víricas) o crónicas (micobacterias o clamidias).
Ante el aislamiento de C. pseudotuberculosis es importante confirmar la identificación a nivel de especie, para diferenciarlo de corinebacterias que producen cuadros similares (Corynebacterium imitans) y de otras especies productoras de toxina diftérica, como Corynebacterium diphteriae (C. diphteriae) y Corynebacterium ulcerans1. La prueba ureasa positiva lo diferencia presuntivamente de C. diphteriae2, siendo necesarias técnicas no convencionales para una identificación correcta, como secuenciación de los genes rpoB o 16S rRNA o MALDI-TOF1,3.
La linfadenitis producida por C. pseudotuberculosis es una enfermedad poco frecuente en humanos. Afecta principalmente a varones, previamente sanos, trabajadores rurales adultos que están en contacto con ganado ovino y caprino4–6. La transmisión principal es a través de lesiones cutáneas por contacto directo (animales o sus productos) o contacto con ambientes contaminados6. Esta infección también se ha asociado con el consumo de productos lácteos crudos del ganado contaminado, así como inhalación de aerosoles que contienen la bacteria5–7. La ubicación cervical de las linfadenopatías sugiere la transmisión oral del microorganismo a través de leche cruda del ganado contaminado8. A pesar de que la paciente no refirió ingesta de productos lácteos crudos, pensamos que es la vía más probable de adquisición debido a que en nuestro medio es frecuente el consumo de quesos de cabra sin pasteurizar.
Las manifestaciones más frecuentes de la enfermedad son adenopatías supurativas en distintas localizaciones (axilares, inguinales y cervicales), fiebre y/o mialgias con evolución crónica o subaguda9,10.
El tratamiento se llevó a cabo con macrólidos, según recomendaciones de las guías terapéuticas. En ocasiones es necesario el drenaje quirúrgico del ganglio para asegurar una evolución favorable del cuadro7,8. En nuestro caso no fue necesario.
Destacamos la importancia de la identificación de este agente etiológico infrecuente ante casos clínicos similares, para un correcto tratamiento y resolución del cuadro.